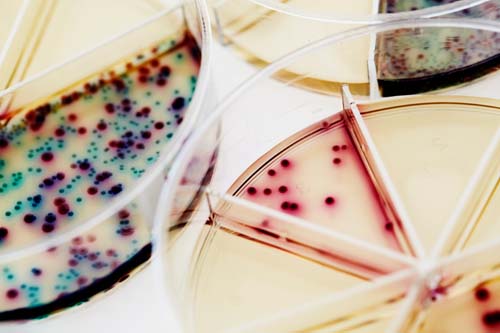

Flexicult Vet, 3stk
Flexicult ® Vet er et enkelt 24-timers dyrkningskit til diagnostisering av urinveisinfeksjoner hos hunder og katter. Flexicult ® Vet gjør det enkelt, raskt og billig å identifisere bakterier samt å velge riktig type antibiotika.
Flexicult ® Vet er utformet som en agarplate med forhøyede kanter, oppdelt i felter med skillevegg og et tilhørende lokk. Det er et stort tellefelt til semikvantitativ bestemmelse og 5 mindre felter med hver sin antibiotika: ampicillin, amoxicillin / klavulansyre, oxacillin, Enrofloxacin og trimetoprim / sulfamethizole.
Agarplaten inneholdet et kromogent substrat som får bakteriekolonier eller agar til å fremstå med forskjellige farger avhengig av hvilke bakterer det er. Jo flere bakterier som er i urinen, jo flere bakterier vil det være i telleområdet. Ved å sammenligne tettheten av bakterier, er det mulig å få en indikasjon på antall bakterier i urin (CFU /ml).
En inkubator er nødvendig for å dyrke urinen.